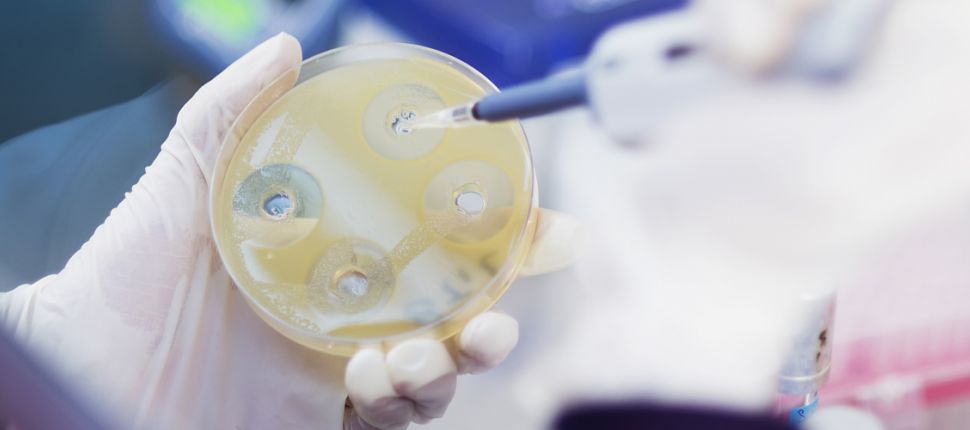

بيئة: ملوّثات الغذاء الميكروبيولوجية
رولا فقيه
التسمم الغذائي تسببه كائنات حية دقيقة لا ترى بالعين المجرَّدة، قد تكون بكتيريا،
فيروسات، طفيليات أو فطريات، وذلك عن طريق السموم التي تفرزها هذه الجراثيم في
الأغذية وداخل الجهاز الهضمي للإنسان أو نتيجة تكاثر هذه الجراثيم في الأطعمة، إذا
توافرت لها العوامل المناسبة لنموِّها وتكاثرها مثل الرطوبة، الحرارة المناسبة وعدم
احترام قواعد الصحة والنظافة. فساد المواد الغذائية ظاهرة للتغيرات الفيزيائية
والكيميائية التي تؤثِّر على خواص الغذاء وتسبب بالتالي أعراضاً مرضية تصيب الإنسان
وتسبب له واقعة صحيَّة تعرف باسم "التسمم الغذائي".
ما هي العوامل الحيوية
المسبِّبة لهذه الحالة؟ وما هي الوسائط الرئيسة الناقلة لهذه الأحياء الدقيقة؟
عناوين عدَّة توصلنا إلى أمر واحد مفاده أنَّ اتِّباع سلسلة القواعد والمعايير
الصحية في تحضير الغذاء يعتبر الحلّ الأمثل لضمان جودة المنتجات وبالتالي ضمان
خلوّها من أيِّ من الملوثات الميكروبيولوجية الطارئة بذاتها على المواد الغذائية.
* تعريف الملوّثات الميكروبيولوجية
هي الأحياء المجهرية الدقيقة التي تشمل الفطريات والبكتيريا والخمائر, والحيوانات
الدقيقة كالأميبا, والإنزيمات وهي مركبات بايوكيميائية توجد في خلايا الأنسجة
الغذائية نفسها أو تفرز من قبل خلايا الأحياء المجهرية الّتي قد تنشط في ظروف
معيَّنة وبالتالي تسبِّب تحللاً في مكوِّنات الأغذية وبالتالي ظهور علامات التلف
التي تتمثَّل في تغير جليّ المعالم في طبيعة قوام ولون وطعم مادَّة المكوّن الغذائي.
الأسباب الرئيسة للأمراض المنقولة بواسطة الغذاء
1. عدم تبريد الطعام المطهو بالطريقة الصحيحة.
2. عدم طهو الطعام بالطريقة الصحيحة وبدرجات الحرارة الكافية لقتل الجراثيم المسببة
للأمراض.
3. وجود مرض معدٍ عند أحد العاملين، أوعدم اتباع مقاييس النظافة الشخصية عند
العاملين في مجال خدمات الطعام.
4. ترك المواد الغذائية ضمن درجات الحرارة (4-60 م°) الّتي تعتبر درجات الحرارة
الخطرة المناسبة لنمو وتكاثر الجراثيم بشكل سريع، لفترة زمنية تزيد عن 4 ساعات.
5. خلط طعام مطهو بطعام غير مطهو.
6. عدم تسخين الطعام المطبوخ بالطريقة الصحيحة وبدرجات الحرارة الكافية 73.9 ْم
لقتل الجراثيم المسببة للأمراض.
7. انتشار التلوث الخلطي (Cross Contamination) وذلك باستعمال الأدوات الملوثة من
مواد غذائية أخرى كاستعمال الأدوات المستعملة في تقطيع اللحوم في تحضير السلطات.
* الحرارة
تحتاج الأحياء الدقيقة التي تسبب التسمم الغذائي إلى درجة حرارة ما بين 5 إلى 60
درجة مئوية وهو ما يسمى بالمنطقة الخطرة Danger Zone.
* الوقت
عامل الوقت مهم جداً في إجراءات الوقاية الصحية الضامنة لسلامة الغذاء, فعملية
تكاثر الأحياء الدقيقة تأخذ الإطار الثنائي وفقاً للجدول المدرج أدناه:
* الوسائط الرئيسة الناقلة للأحياء الدقيقة
• الغبار، الشعر، الرذاذ الهوائي، إفرازات من الجسم. تستقر هذه على الأطعمة
المكشوفة غير المغلقة بالطريقة الصحيحة.
• عدم اتباع قواعد النظافة الشخصية.
• الماء الملوث عن طريق مياه الشرب، الثلج أو أية مشروبات أخرى.
• الأدوات الملوثة كالأواني وغيرها من أدوات الطبخ وتقديم الطعام، أو الأدوات
العامة مثل مقابض الحنفيات، مقابض أبواب الحمامات، القطع النقدية، المفاتيح،
الأقلام وغيرها.
• عدم غسل اليدين بعد لمس المواد الغذائية الخام غير المطهوة مثل البيض، اللحوم،
الخضار والفواكه وعدم ارتداء القفازات المستهلكة لمرة واحدة عند إعداد الغذاء في
المطاعم.
• الأتربة، عدم غسل المواد الغذائية جيداً عند تجهيزها وخصوصاً الخضار والفواكه
وذلك للتأكد من إزالة أي أثر للمبيدات، الأتربة أو الأسمدة وخصوصاً العضوية منها
والتي تلامس الخضار والفواكه.
• الحشرات، القوارض والحيوانات الأليفة والتي تعتبر من أهم مسببات نقل الجراثيم
للمواد الغذائية مثل الذباب، الصراصير، الفئران والقطط.
(1) Food Service Associates, The Complete HACCP Manual for Institutional
Food Service Operations, 2nd edition
(2) SOP Series 300 Food Production Standards, Forms and References
(3) SOP 300.1 Standards of Food Production
(4) SOP 300.5 Food Preparation and Cookery
(5) SOP 300.6 Food Quality and Salfety.



















